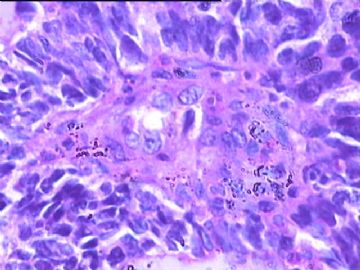
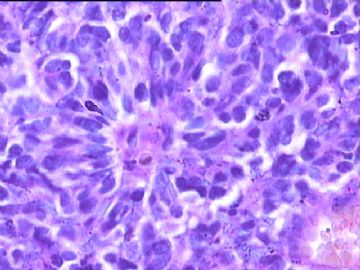

| 图片: | |
|---|---|
| 名称: | |
| 描述: | |
- 额叶占位,胶母典型不?
-
This is certainly a WHO grade IV malignant neoplasm. While most likely a glioblastoma, I would carefully rule out PNET by staining for GFAP and neuronal markers such as synaptophysin, NeuN and NSE. Rarely, PNET may shows marked pleomorphism and indistinguishable from glioblastoma on HE stain.

聞道有先後,術業有專攻
-
PNET and GBM are both WHO grade IV, but they have distinct different biologic behavior. For instance, PNET is more likely to spread by CSF seeding at the beginning or at recurrence after resection. Response to various chemotherapeutic agents is also different between the two. Therefore it is important to distinguish them when you can.

聞道有先後,術業有專攻
-
zhang197510 离线
- 帖子:409
- 粉蓝豆:2971
- 经验:448
- 注册时间:2009-03-22
- 加关注 | 发消息
-
liangjinjun 离线
- 帖子:2328
- 粉蓝豆:2
- 经验:2457
- 注册时间:2007-08-07
- 加关注 | 发消息
-
redsnow007 离线
- 帖子:329
- 粉蓝豆:5
- 经验:999
- 注册时间:2008-01-01
- 加关注 | 发消息